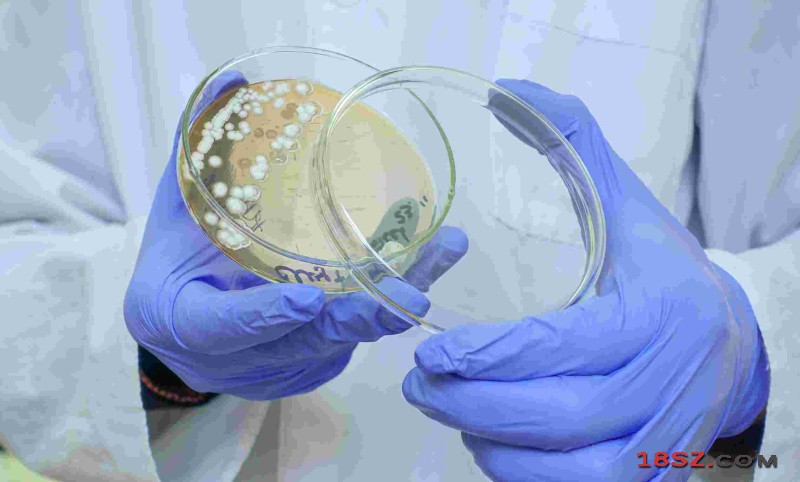

瑞典卡罗琳医学院日前发布新闻公报说,该院研究人员开发出一种快速、低成本的检测细菌耐药性技术,有望帮助临床医生更早作出用药决策。
公报说,传统检测通常需要先培养细菌,再观察菌群在抗生素作用下是否继续生长,往往耗时较长。而这项名为s5PSeq的检测技术,可检测细菌在接触抗生素后,核糖核酸出现的分子反应,因此无需等到菌群出现可见的生长差异,就能判断出细菌对药物是敏感还是耐药。

实验显示,在用红霉素处理艰难梭菌仅10分钟后,这项技术就能够区分对红霉素耐药或敏感的菌株。 这项技术的另一优点是与便携式纳米孔测序设备兼容。这类设备目前已在许多医疗诊断和科研实验室应用,因此这项技术有望较方便地纳入常规临床检测流程。 研究人员称,快速检测对于有效应对抗生素耐药性十分关键,在过去的医疗诊断流程中,有时需要数天才能获得检测结果,新技术有望将这个时间大大缩短,接下来将评估该技术在真实临床环境中的应用潜力。 相关研究成果已发表于美国学术期刊《细胞报告·方法》。

中国能建
蓝海永兴
HUAWEI
天桥起重
Dahua Technology
陕煤化工集团
3M制造业
Gemtique
中国石油
延长石油
IAA Show
LASTON
PALEXPO
German Machine Tool Builders Association
维远光伏产业
IFEMA
吉祥星科技
Iteca Exhibitions
陕西有色金属
天元化工
中油工程
首匠装饰工程
长城润滑油
中杭贸易
PV EXPO
Expocentre
HealthCare
Hannover Messe
KUNVII
Time Out Group
National Media
大唐旗舰店
Dowpol Chemical
MFV Expositions
TOSHIBA
神木职教中心
2021年秋季艺术品拍卖会水墨葡萄90万成交
上海进博会:潮货云集 包罗万象
杜塞尔多夫国际高尔夫用品展览会
中国企业助埃及女孩实现梦想
西丽综合交通枢纽“顶级设计”方案夺冠
Glee Birmingham 2023
商务部:将制定行动计划 推进贸易高质量发展
40周年庆典今天揭幕 16分钟燃情大片献礼深圳
2026第十九届烟台国际核电工业及装备博览会图集
美国华府暴动 示威者攻入国会大厦 造成4死
2019年冬季意大利米兰国际时尚配饰和珠宝展览会
排球——女排世界杯:中国队捧杯
河南南阳发现5000多年前大型玉石器生产基地
联合国联合国安理会8日在安理会厅举行
新冠病毒灭活疫苗获批进入临床试验
Exhibit at Power Gen Expo
2021中国环博会-亚洲旗舰环保展
Facial tissue
2026年中东(阿布扎比)国际石油展商务团ADIPEC
老子语录-为天下
上海国际医疗器械展2024年6月26-28日举办
2024年上海美博会-2024年上海浦东美博会
专供地铁等基建扁钢
长征者-老红军钟铨铭油画
意大利里米尼城市介绍
纽伦堡 - 玩具都城
慕尼黑 - 伊萨尔河畔的酒都
法兰克福 - 欧洲金融中心
迪拜 - Dubal
俄罗斯 - 战斗民族和套娃的国家
葡萄牙 - 软木塞之乡
西班牙 - 斗牛士的故乡



